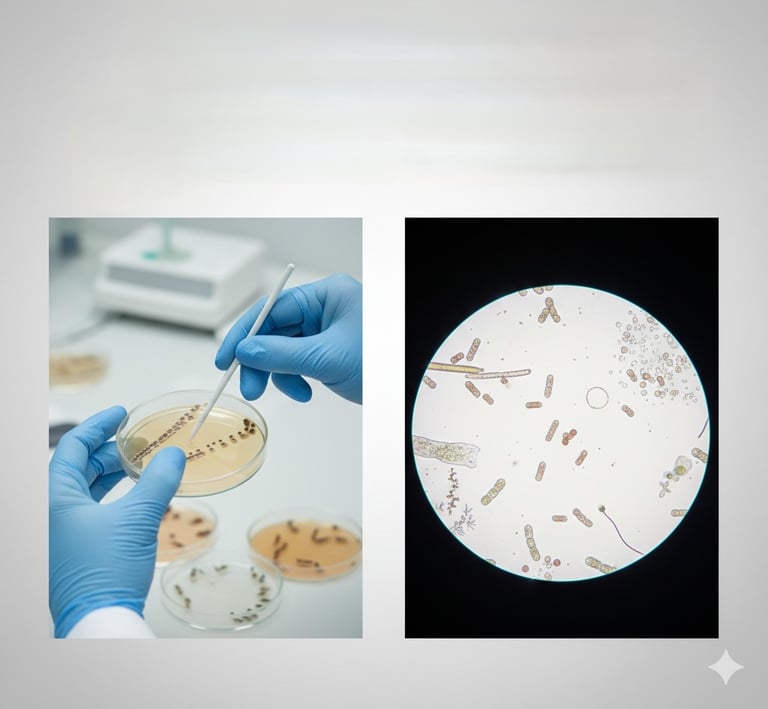
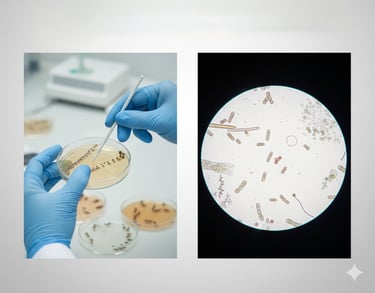

Microbiological Analysis
Microbiological Analysis involves the examination of microbial populations in water and animal samples to detect harmful bacteria (e.g., Vibrio) and other microorganisms. This analysis helps assess the microbial health of the aquatic environment and identifies potential disease-causing agents
Get in touch

MSortia LLP
© 2025 MSortia LLP
M/S. MSortia LLP,
RISE (RUSA Innovation and Start up Ecosystem),
CUSATECH Foundation,
Amenity Centre, Cochin University of Science and Technology,
Cochin -682022
Powered by Mapstrix Solutions
